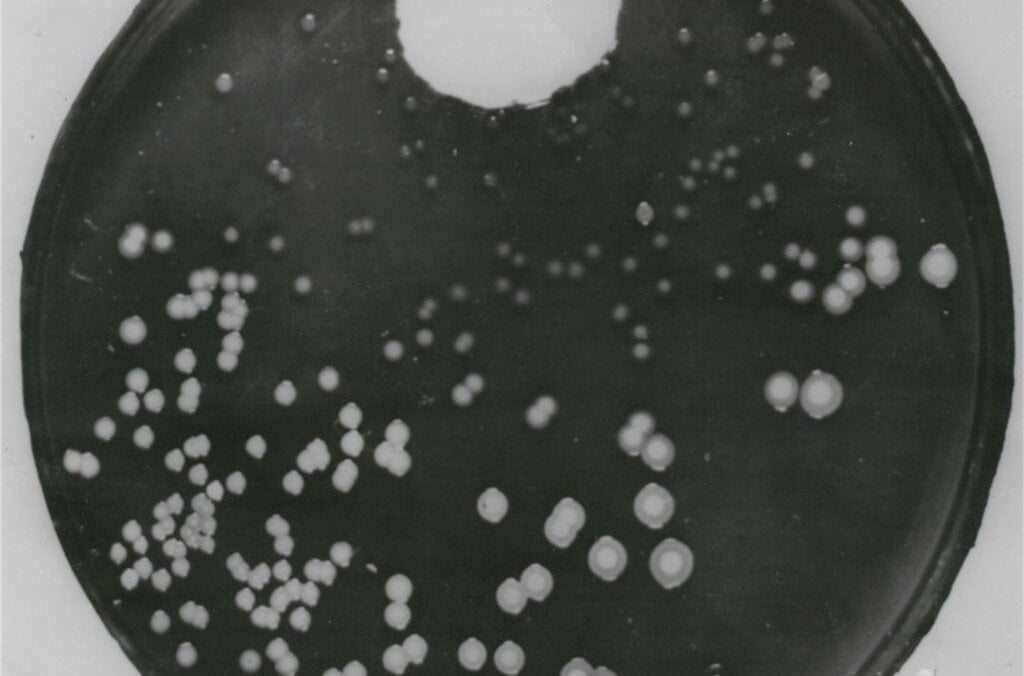
Penicillin plate

As bacteria become resistant to existing antibiotics, we are running out of drugs to treat infectious diseases. This is a problem that Alexander Fleming, who discovered penicillin, foresaw already in 1945. Today the hunt is on to find new antibiotics with the potential to save millions of lives.
At a glance
- Antimicrobial resistance (AMR) is a global health crisis, with predictions that 10 million people per year could die from drug-resistant infections by 2050.
- Alexander Fleming’s discovery of penicillin revolutionised medicine. Fleming warned in 1945 that improper use of antibiotics could lead to antibiotic resistance.
- Scientists are searching for new antibiotics in various environments, such as deserts, oceans, and even within the human body, to combat AMR.
Equipped with sunglasses and blue latex gloves, microbiologist Cristina Dorador kneels on the Atacama Desert salt flats in Chile. Using a sampling spoon, she carefully scrapes up soil, collecting it into tubes.
Dorador, who was born and raised nearby, is devoted to finding new medical treatments for infectious diseases. In the desert, there are microorganisms that survive extreme conditions and produce substances that could be used to create new antibiotics.

Given the growing problem of antibiotic-resistant bacteria, which causes about five million deaths globally per year, this is an important quest. Without new antibiotics it is estimated that, by 2050, ten million people a year will die of previously treatable infections.
Today this is a major health problem, but warnings of antimicrobial resistance were already being made in the 1940s.
Penicillin – the wonder drug that revolutionised medicine
Alexander Fleming was a Scottish bacteriologist who early on in his career became interested in the natural bacterial action of blood and antiseptics. In the autumn of 1928, while working on the influenza virus, he cultured bacteria on plates and left them in his lab.

On his return, he found that mould had developed accidentally on a staphylococcus culture plate and that the mould had created a bacteria-free circle around itself. This inspired him to perform further experiments, and he found that a mould culture prevented growth of staphylococci, even when diluted 800 times. He named the active substance penicillin.
“Fleming’s genius was that he noticed something that others might have missed. He saw something that didn’t fit into a pattern and used his scientific knowledge to come to conclusions about what it was,” says Kevin Brown, trust archivist and curator at the Alexander Fleming Laboratory Museum in London.
At first, penicillin received a lukewarm response, as it was unstable and difficult to isolate. However, in the midst of WWII, Oxford scientists Ernst Boris Chain and Howard Florey managed to produce a pure form of penicillin, which was used to treat wound infections, pneumonia, and other bacterial diseases among soldiers fighting the war.

By 1944 there was enough penicillin for widespread use on the battlefields of Europe, and the following year the “wonder drug” was available without restriction in the USA for civilians.
“There was now a way of controlling infection, which revolutionised medicine.”
Kevin Brown, trust archivist and curator at the Alexander Fleming Laboratory Museum in London
The post-war years kicked off a “penicillin mania” in the Western world, paving the way for many other antibiotics.
In 1945, the Nobel Prize in Physiology or Medicine was awarded jointly to Fleming, Chain and Florey. However, in his Nobel Prize lecture given the same year, Fleming acknowledged the danger of antibiotic resistance in microorganisms. He warned that some bacteria could survive and become resistant if the dosage was too low. He was proven right.

New ways of fighting the AMR epidemic
Antimicrobial resistance (AMR) occurs when bacteria, viruses, fungi and parasites no longer respond to antimicrobial drugs, making them ineffective. As a result, infections become difficult or impossible to treat, with severe or deadly consequences.
Our misuse and overuse of antimicrobials in humans, animals and plants are the main drivers in the development of drug-resistant pathogens.
While there is insufficient research in the face of rising levels of resistance, urgent actions and research are needed, according to the World Health Organization. Since the 1980s, no new antibiotics classes have reached the market and innovation in the field has stagnated. Scientific challenges, financial hurdles and lack of know-how are some of the reasons why so few new antibiotics are in the development pipeline.
During the ‘Golden Age’ following the penicillin discovery, new natural product (NP) antibiotic classes were discovered almost on a yearly basis. However, the supply of new NP classes from easy-to-cultivate bacteria compounds eventually came to a halt.
In recent years, the field has switched focus to under-explored environments. Researchers are investigating a diverse range of environments and organisms – from the seabed of the Bahamas to leafcutter ants – in the hunt for new antibiotics. Reports of potential new antibiotic classes appear regularly. In March 2025, Nature published findings about a new molecule – with the potential to kill drug-resistant bacteria – discovered in a soil sample from a backyard in Ontario.
Only a fraction of Earth’s soils have been sampled for antibiotic producers. The Atacama Desert, where Cristina Dorador collects soil samples, is one of the potential hunting grounds.
“The salt flats are life. And they are the key to saving life in the future.”
Cristina Dorador, professor
New research also suggests that the human body itself might be a potential source for candidate molecules to develop into new antibiotics. Genome mining is another tool in the fight against AMR.
WHO adopted its action plan on antimicrobial resistance in 2015, and many countries and organisations have initiated efforts. Several industry initiatives, as well as collaborations between universities and pharmaceutical companies, are also underway.
After issuing his own warnings, Fleming would not have been surprised to know of today’s problems, says Brown.
“He was aware that future problems were on the horizon. I think he would have definitely approved of modern efforts to combat antimicrobial resistance,” he adds.

Q&A: Alexander Fleming
Learn more about Alexander Fleming who discovered penicillin.
Read more: Antibiotics and the Nobel Prize
There are a number of other Nobel Prize-awarded medications against infectious diseases.
Selman Waksman and his colleagues discovered streptomycin, a substance used to treat tuberculosis and other diseases. Waksman was awarded the Nobel Prize in Physiology or Medicine 1952.
2015 medicine laureates Satoshi Ōmura and William Campbell discovered avermectin, a refined form of which used for river blindness and other parasitic infections.